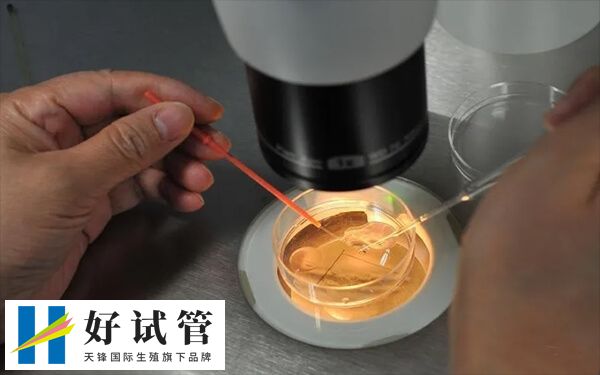
取出2个成熟卵子的怀孕几率因人而异

取了2个卵成功率有多少
在试管婴儿治疗中取得了2个卵子,一般相比正常来说是比较少的,但仍然有一定的成功率,如果患者的卵子质量好,且子宫内膜环境,能配成相对质量好的胚胎,那么移植可有40%的妊娠几率。但如果取卵的卵子质量差,配成的胚胎差,且身体状态也不好的情况下,移植妊娠的几率可能只有20%左右,具体因人而异。
做试管取了2个卵怀孕几率
在试管婴儿过程中,患者取出2个成熟卵子的怀孕几率,通常还要取决于多个因素,包括卵子的质量、胚胎培育情况、植入技术及患者个人身体状态等。
- 一般情况下,若是患者年龄在35岁以下,取出的2个卵子质量比较好,且配成的胚胎发育潜力好,那么移植怀孕的几率则相对较大,大概在40%左右;
- 如果患者为高龄女性,那么做试管取了2个卵的情况下,怀孕几率可能会比较低了,大概在30%或是20%左右,具体还要根据患者实际情况进行判断。
做试管取了2个卵怀孕几率因人而异,不过在多数情况下,做试管取了2个卵怀孕几率是相对较低的,毕竟在理论上,增加卵泡的数量,会相对增加成功率,但最后还要看取了2个卵的成熟度和质量,如果这两个卵子质量比较好,且与精子结合后发育潜力好,那么也会相应增加怀孕的几率。
做试管取了2个卵怎么办
如果在试管婴儿治疗中取得了2个卵子,虽然这个数量相对于常见的获卵数量较少,但仍然有怀孕的可能性。但要注意以下几点:
1、继续治疗:建议继续按照医生的建议进行接下来的治疗周期,包括胚胎培养和移植;
2、身体护理:在取卵后,应注意身体的护理,避免剧烈运动,同时保持健康的饮食和生活习惯,帮助身体更好地恢复,这样可以提高胚胎移植的着床率;
3、定期检测:在移植胚胎后,建议按照医生的建议进行定期的血液中人绒毛膜促性腺激素水平的检测,以确认是否成功妊娠。





